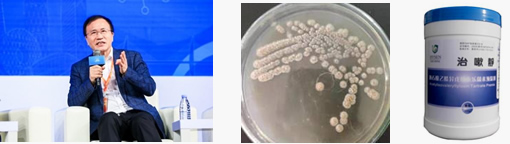

In 1961, the first generation of animal-specific macrolide antibiotics, Tylosin, was discovered by American scientists from Streptomyces fradiae isolated for the first time in Thailand.

In 1961, the first generation of animal-specific macrolide antibiotics, Tylosin, was discovered by American scientists from Streptomyces fradiae isolated for the first time in Thailand.

In 1973, the British company Elanco developed the second generation of animal-specific macrolide antibiotics, Tilmicosin.

In 1980, Japanese scientists first reported the third generation of animal-specific macrolide antibiotics, Tylvalosin tartrate.

Scientists Okamoto et al. developed Tylvalosin tartrate based on Tylosin. A comparison revealed that adding an acetyl group and an isovaleryl group to specific sites on Tylosin enhanced its antibacterial activity.

In 1993, Akria Arisawa and other scientists used molecular biology techniques to reduce the intermediate link in the production of Tylvalosin tartrate by Streptomyces thermophilus and increased the yield of Tylvalosin tartrate. They also elucidated the roles and mechanisms of the acyB1 and acyB2 genes in the biosynthesis of Tylvalosin tartrate.

In 1997, Huang et al. first systematically optimized the fermentation process of Tylvalosin tartrate in shake flasks and 3L fermenters. Building upon this, they further scaled up the process to 200L fermenters, achieving a fermentation level of 13.8g/L for Tylvalosin tartrate. This advancement significantly increased the yield of Tylvalosin tartrate, making large-scale production feasible.

In 2001, Huang et al. further optimized the feeding strategy of Tylosin in the fermentation process of Tylvalosin tartrate using a fermentation kinetic model on a 30L fermenter. This resulted in a 30% increase in fermentation level compared to previous methods. They extended this model to a 60-ton fermenter, enabling the large-scale production of Tylvalosin tartrate. Consequently, the new generation macrolide antibiotic Tylvalosin tartrate was brought to market.

In 2017, Wu et al. conducted a systematic study on the biotransformation, purification, and identification of Tylvalosin tartrate, further consolidating the foundational research of Tylvalosin tartrate.

In 2007, Hvsen Biotech collaborated with the team led by Academician Zi-Xin Deng from Wuhan University, dedicating 8 years of intensive research. They traveled across more than 30 provinces and cities in China, collecting over 300 strains of bacteria. From this collection, they screened and selected a variant of Streptomyces hawaiiensis, named Wuhan strain 0915 (patent number: ZL201010565652.1). Concurrently, they optimized the fermentation process, reducing the fermentation cycle from 7 days to 5 days while maintaining the fermentation level of Tylvalosin tartrate. This technological breakthrough achieved a significant milestone, breaking the technical monopoly held by foreign companies.


In 2011, Hubei Hvsen successfully commenced production of Tylvalosin tartrate, becoming the third global manufacturer of Tylvalosin tartrate.
In 2014, Hvsen Biotech made a breakthrough in the technical limitations of its Tylvalosin tartrate preperations product. It introduced rapid water-soluble technology for the first time, enabling a concentration of up to 50 times (based on Tylvalosin tartrate: dosage of 100g/ton of water), making it one of the fastest water-soluble Tylvalosin tartrate products at the time, with stable water solubility. After 24 hours in an aqueous solution, the content of effective ingredients of Tylvalosin tartrate decreased by less than 2%, which was highly sought after by numerous farmers for its practicality.
In 2016, the annual production capacity of the Tylvalosin tartrate production workshop was expanded to 60 tons.

In 2019, the annual production capacity of the Tylvalosin tartrate production workshop was further expanded to 160 tons.


In 2023, the trial production of a Tylvalosin tartrate production line with an annual output of 600 tons will commence. Simultaneously, a brand-new generation of Tylvalosin tartrate premix has been launched, continuing the robust traits of its predecessor while significantly upgrading its water solubility, palatability, and other aspects. Utilizing unique fermentation processes and patented extraction technologies, the water solubility can reach up to 100 times concentration (based on Tylvalosin tartrate: dosage of 100g/ton of water), completely dissolving in just 5 minutes with a 150 times concentration dissolving in 10 minutes. The medication does not adhere or clump, marking the official start of the era of high-speed water-soluble Tylvalosin tartrate.
SootheCough from Hvsen has garnered extensive recognition among frontline farmers for its outstanding quality in treating swine mycoplasma pneumonia, enteritis, and swine dysentery.
Research led by Stuart and colleagues at the University of Cambridge found that Tylvalosin tartrate effectively inhibits the replication of Porcine Reproductive and Respiratory Syndrome Virus (PRRSV). Based on this, HVSEN Tylvalosin tartrate premix was clinically used to suppress PRRSV replication in pigs and control secondary infections.

The combination of Tylvalosin tartrate premix and mixed Vitamins Lvyitai treatment protocols, was developed for the prevention and control of PRRSV. This combination not only controls the pathogen but also combats stress, supplements key nutrients for pigs, and improves intestinal digestive function.

After several years of research led by Professor Zhou Rui’s team at Huazhong Agricultural University, The new treatment protocols (Tylvalosin tartrate premix+ mixed vitamins Lvyitai +Poria polysaccharide powder) was developed for the prevention and control of Porcine Reproductive and Respiratory Syndrome (PRRS). This program not only inhibits virus replication, reduces inflammation damage, combats stress, and supplements key nutrients but also repairs and enhances the immune system, providing comprehensive protection against the threat of PRRS to pig herds.

Currently, the program has been widely promoted and implemented in more than 20 large-scale pig farming corporations and tens of thousands of commercial pig farms nationwide, yielding remarkable results.
